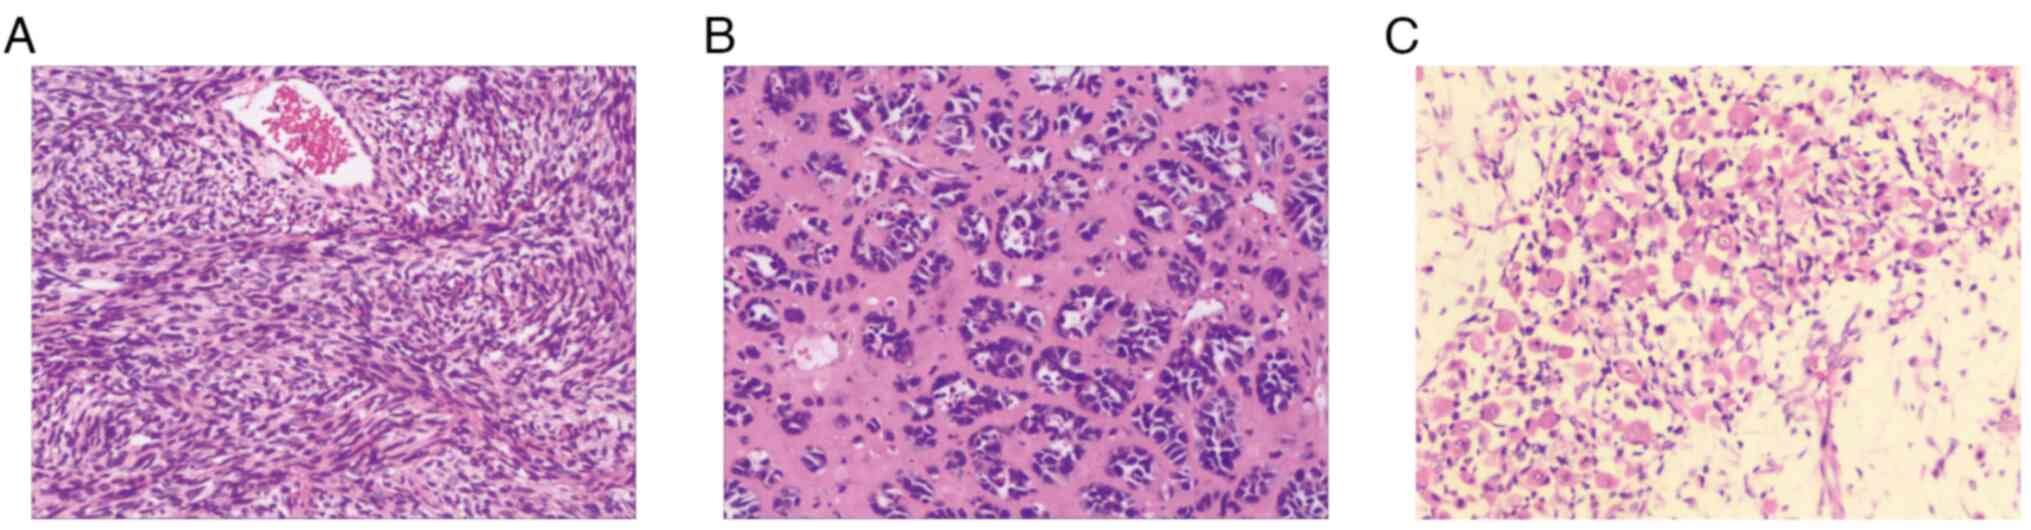

Introduction
Malignant peripheral nerve sheath tumors (MPNSTs)
are rare soft-tissue sarcomas with an incidence of 0.001% in the
general population as recorded in the Surveillance, Epidemiology,
and End Results database (1). The
global 5-year overall survival rate, 5-year event-free survival and
local recurrence rate were reported to be 49, 37 and 38%,
respectively (2). The primary risk
factor for developing MPNST is neurofibromatosis type-1 (NF1), with
~10% of patients with NF1 experiencing this condition in their
lifetime (3). In addition, ~5% of
MPNST cases are induced by radiation (4). Originating from the sheaths of
peripheral nerves, MPNST is a high-grade tumor made up of spindle
cells (5), which is difficult to
diagnose and relies on pathological results (6). According to World Health Organization
standards, MPNST can be divided into several types, including
low-grade MPNST, high-grade MPNST, epithelioid MPNST, perineurial
MPNST and malignant melanotic schwannian tumors (7). Its differential diagnosis includes
melanoma, clear cell sarcoma and epithelioid sarcoma (8). Le Guellec et al (9) reported that 29 tumors (18.1%) that
were initially diagnosed as MPNST were reclassified on the basis of
histological review, immunohistochemistry and molecular analysis.
Goertz et al (10) studied a
group of 65 cases of MPNST, for which the diagnosis of 32.3% of
cases needed to be amended, indicating that the diagnosis of MPNST
is challenging. Currently, there is no established treatment for
MPNST, and most available options are derived from methods used to
treat soft tissue tumors. Although surgery is the treatment of
choice for MPNST, its aggressive nature makes achieving a full or
wide resection challenging. The use of radiation, chemotherapy and
targeted therapy for MPNST is still limited and uncertain, because
of the lack of treatment methods with proven benefit (11).
MTT is a rare, highly aggressive subtype of MPNST
with rhabdomyosarcomatous differentiation, and represents ~5% of
all MPNST cases (1). To date, ~248
cases of MTT have been reported in the literature worldwide and the
male-to-female incidence ratio is 1.5:1 (12). MTTs are more common in the head,
neck, trunk and limbs (13), while
mediastinal lesions are rarely observed. To date, ~20 cases of
mediastinum MTT have been reported in studies published in English
(14). MTTs are more common in
middle-aged individuals and rare in children (15), with <50 cases in children
reported to date (16,17). Compared with MPNST, MTT has a higher
degree of malignancy, is more invasive and is less common in
clinical practice (18). The
outcome of MTT remains poor after comprehensive surgical and
chemoradiotherapy treatment (14).
Owing to the rarity of this disease, no consensus exists for the
treatment of MTT. The current study presents a case of an MTT of
the axilla and describe the patient's clinical features, diagnosis
and treatment. The purpose of the present study is to provide
clinical strategies for the diagnosis and treatment of MTT.
Case report
A 60-year-old female patient presented at The
Liuzhou Worker's Hospital (Liuzhou, China) in September 2023,
reporting a tingling sensation in the axilla, secondary to a mass
in the left axilla that had increased in size over the past 20
years. Physical examination demonstrated that the mass had a tough
texture, clear boundaries with surrounding tissues and no local
rupture; additionally, it was firm and accompanied by mild
tenderness. Magnetic resonance imaging (MRI) demonstrated a left
axillary lesion measuring 5.7×5.7×7.7 cm (Fig. 1), a clear boundary of the lump, low
T1-weighted imaging (WI), high T2WI, uneven and significant
enhancement on enhanced scanning and compression of the axillary
arteries and veins. Therefore, a nerve sheath tumor was suspected.
The patient's lactate dehydrogenase (LDH) level was within the
normal range at 137 U/l (normal range, 120–250 U/l). Throughout the
treatment process (from September 2023 to October 2024) the LDH
level remained within the normal range, and routine blood and
biochemical indicators were normal. Complete surgical excision of
the left axillary mass was performed in September 2023. Grossly,
the tumor measuring 5.0×4.7×6.5 cm had a capsular sheath with
adhesion of the axillary artery and vein, and the ulnar and median
nerves.
Immunohistochemical analysis was performed using
5-µm paraffin-embedded tissue sections that had been fixed with 10%
neutral formalin at room temperature for 24 h. The sections were
baked at 65°C for >2 h, dewaxed three times with xylene and then
hydrated with a series of alcohol solutions. For antigen retrieval,
sections were heated in EDTA buffer (pH 9.0) in a 100°C water bath
for 20 min and were then blocked with 3% hydrogen peroxide at room
temperature for 10 min. The tissue sections were then incubated
with a ready-to-use cytokeratin 20 antibody (Ks20.8; cat. no.
Kit-0025), spectral cytokeratin antibody (AE1/AE3; cat. no.
Kit-0009), vimentin antibody (MX034; cat. no. MAB-0735), H3K27Me3
antibody (RM175; cat. no. RMA-0843), S-100 antibody (4C4,9; cat.
no. Kit-0007), Sox-10 antibody (EP268; cat. no. RMA-0726), desmin
antibody (MX046; cat. no. RMA-0766), smooth muscle actin (SMA)
antibody (1A4; cat. no. Kit-0006), Ki67 antibody (MXR002; cat. no.
RMA-0731), integrase interactor 1 (INI-1) antibody (MRQ-27; cat.
no. MAB-0696), programmed cell death-ligand 1 (PD-L1) antibody
(MXR025; cat. no. RMA-1057), epithelial membrane antigen (EMA)
antibody (E29; cat. no. Kit-0011), myogenin differentiation 1
(MYOD1) antibody (MX049; cat. no. MAB-0822), CD34 antibody (MX123;
cat. no. MAB-1076), Bcl-2 antibody (MX022; cat. no. MAB-0711) and
HMB-45 antibody (HMB45; cat. no. MAB-0098) (all from Fuzhou Maixin
Biotechnology Development Co., Ltd.) for 1 h at room temperature,
or with PBS (Fuzhou Maixin Biotechnology Development Co., Ltd.) as
a negative control. Detection of primary antibody binding sites was
carried out using the MaxVision™ HRP-Polymer anti-Mouse/Rabbit IHC
Kit (cat. no. KIT-5030; Fuzhou Maixin Biotechnology Development
Co., Ltd.) at room temperature for 1 h. DAB was used for color
development. Hematoxylin counterstaining was also performed at room
temperature for 2 min. The tissue sections were then sealed and
observed under a light microscope (ECLIPSE Ci-L; Nikon
Corporation). This process used a fully automated
immunohistochemical staining instrument (Lumatas; Fuzhou Maixin
Biotechnology Development Co., Ltd.). Hematoxylin and Eosin
staining of the tumor sample was performed at room temperature for
45 min and was observed under a light microscope (ECLIPSE Ci-L;
Nikon Corporation), which displayed a heterogeneously
differentiated tumor consisting of spindle-shaped cells with a high
mitotic index (Fig. 2A), gland-like
epithelioid cells (Fig. 2B), focal
necrosis and differentiated areas of rhabdomyosarcoma (Fig. 2C). Immunohistochemistry demonstrated
that the neoplasm was positive for vimentin (Fig. S1A), EMA (Fig. S1B), MYOD1 (Fig. S1C), S-100 (Fig. S1D), Sox-10 (Fig. S1E), CD34 (Fig. S1F), Bcl-2 (Fig. S2A), desmin (Fig. S2B), SMA (Fig. S2C), INI-1 (Fig. S2D) and mosaic loss of H3K27me3
expression (Fig. 3A). The Ki-67
proliferation index was 75% (Fig.
3B). Markers such as pancytokeratin (CKpan; Fig. 3C), CK20 (Fig. 3D), HMB-45 (Fig. S2E) and (PD-L1 (Fig. 3E) were negative.
 | Figure 3.Representative immunohistochemistry
images of the tumor sample. Immunohistochemistry showed (A) mosaic
loss of H3K27me3 expression (magnification, ×10; magnification in
subpart, ×4.44) and (B) a Ki-67 proliferation index of 75%
(magnification, ×10; magnification in subpart, ×4.44).
Immunohistochemistry was negative for (C) pancytokeratin
(magnification, ×10; magnification in subpart, ×4.44), (D) CK20
(magnification, ×10; magnification in subpart, ×4.44) and (E)
programmed cell death-ligand 1 (magnification, ×10; magnification
in subpart, ×4.44). (F) Next-generation sequencing identified
mutations present in the NF1 tumor suppressor gene (915 reads were
sequenced, 789 of which were normal base C, and 22 mutated to T,
denoted as c4084C>T). (G) Fluorescence in situ
hybridization for SS18/SYT gene rearrangement was negative
(magnification, ×100; magnification in subpart, ×2.74). |
The VAHTS Universal DNA Library Prep Kit for
Illumina V4 (cat. no. ND610-02; Nanjing Novozymes Biotech Co.,
Ltd.) was used to prepare the patient's surgical axillary tissue
specimen DNA samples for sequencing. The Qsep 100 fully automated
nucleic acid and protein analysis system (BiOptic, Inc.) was used
to verify the quality/integrity of the processed samples.
Next-generation sequencing (NGS) was then performed (paired end
sequencing; nucleotide length, 150 bp) using the Novaseq X Series
10B Reagent Kit (300 cycles; cat. no. 20085594; Illumina, Inc.) or
NovaSeq X Series 25B Reagent Kit (300 cycles; cat. no. 20104706;
Illumina Inc.); the loading concentration of the final library was
150 pmol. Vardict 1.8.3 (19) was
used to analyze the data (open source). NGS (Fig. 3F) demonstrated the presence of
mutations in the NF1 tumor suppressor gene (NF1: exon 30
c.4084C>T p.R1362, with a mutation abundance of 2.40%).
To further exclude the diagnosis of synovial
sarcoma, tumor cells underwent fluorescence in situ
hybridization (FISH) detection according to the instructions of the
SS18 gene two-color breakage probe kit (cat. no. FP-055; Wuhan
Kanglu Biotechnology Co., Ltd.,). The FISH interpretation criteria
were as follows: The normal negative signal pattern consisted of
two yellow signals fused with red and green, while the typical
positive signal pattern cosisted of a separated signal of one
yellow, one red and one green (with a red green signal separation
diameter of ≥2 signal points). A total of 100 tumor cells from at
least two tumor regions were counted, and the proportion of
positive signal cells ≥13% was defined as SS18 gene rearrangement
positive. FISH (Fig. 3G) for the
SS18/SYT gene rearrangement was negative. On the basis of
aforementioned findings, the patient was diagnosed with MPNST with
rhabdomyosarcomatous differentiation, also known as MTT. The
patient was staged as pT2N2M0 or IIIA according to the staging
criteria of the 8th edition of the American Joint Committee on
Cancer Staging System (20),
combined with preoperative MRI and postoperative pathology.
A whole-body
18F-fluorodeoxyglucose-positron emission/computed
tomography (18F-FDG PET/CT; Fig. 4) scan was performed 40 days after
surgery and showed an FDG-avid lesion 3.6×3.4×3.4 cm in size in the
left axilla, which was interpreted as early local recurrence.
Secondary surgery could not be considered, as due to the
involvement of the axillary artery and vein there was a risk of
bleeding. Postoperative therapeutics included radiation therapy and
deep hyperthermia; nine-field intensity-modulated radiation was
delivered to the left axilla (46 Gy in 23 fractions over 5 weeks;
Fig. 5) and concurrent deep
hyperthermia was performed three times per week for 5 weeks. Later,
in January 2024, reexamination via MRI confirmed the reduction of
tumor size (2.8×1.1×1.1 cm; Fig.
6A). In February 2024, the patient received oral anlotinib at a
dose of 10 mg daily (before breakfast) for 2 weeks. An MRI
reexamination of the left upper arm indicated that the tumor had
entirely disappeared after 1 cycle (included 2 weeks of being on
the regimen and 1 week off) of tyrosine kinase inhibitor
(TKI)-targeted therapy (Fig. 6B).
The patient developed hypertension following the first cycle of
TKI-targeted administration, which was well controlled after
antihypertensive treatment (nifedipine controlled-release tablets
30 mg orally, once daily). As of the latest follow-up in October
2024, the patient was stable and remained on anlotinib treatment
with good tolerance, with follow-up occurring every 2–3 months.
Discussion
First described by Masson (21) in 1932, MTT is a rare, highly
aggressive subtype of MPNST with rhabdomyosarcomatous
differentiation (22). The etiology
of MTT remains elusive, but there is an association with NF1
mutations (23). In a systematic
literature review of 34 patients and a retrospective, single-center
study of 16 patients, Marcel et al (24) demonstrated that primary MTTs were
large, lobulated tumors with necrotic areas, low T1WI, high T2WI
and heterogeneous enhancement, features which were suggestive but
non-specific, and that they were difficult to distinguish from
other types of MPNSTs on the basis of imaging alone. S-100 and
Sox-10 are specific protein markers of Schwann cells. However, a
study by Karamchandani et al (25) examining protein expression levels of
Sox-10 and S-100 markers in 1,012 specimens, which included 78
cases of MPNST, demonstrated that the sensitivities of Sox-10 and
S-100 protein for the detection of MPNSTs were 27 and 40%,
respectively. The loss of H3K27me3 expression is a sensitive marker
for MTT, with H3K27me3 negativity found in 95% of cases (26).
In the present case, the patient's LDH level was 137
U/l, which is a normal level that may indicate that the patient
could achieve a good prognosis if they actively cooperated with
treatment. Jurisic et al (27) reported that the intracellular
characteristics of LDH enzymes are sensitive indicators of the
cellular metabolic state, aerobic or anaerobic direction of
glycolysis, activation status and malignant transformation, and
that analysis of LDH activity is useful for the early diagnosis and
treatment of tumors. The patient of the present study had no
medical history of the condition NF1 or radiation therapy. MRI
revealed a left axillary lobulated mass measuring 5.7×5.7×7.7 cm,
with low T1WI, high T2WI and heterogeneous enhancement.
Pathological examination suggested that certain tumor areas
exhibited epithelial-like cell differentiation, with a visible
glandular arrangement. Essentially, these areas are sarcoma cells,
some poorly differentiated cell sarcomas often exhibit epithelioid
cells (28). The
immunohistochemical markers CKpan and CK20 in the patient's
epithelium were negative, which can exclude an epithelial origin
(29,30). These findings validated the
diagnosis of a sarcoma and the presence of such cells indicated
glandular elements, which are exceedingly rare (31). The results of immunohistochemistry
demonstrated positive Sox-10 and S-100 staining, and mosaic loss of
H3K27me3 expression, suggesting a diagnosis of MTT. However, the
diagnosis of synovial sarcoma could be fully ruled out, due to the
focal and weak expression of EMA (32). Further genetic testing was therefore
necessary for the present patient. FISH conducted for the SS18/SYT
gene rearrangement was negative, in conjunction with mutation of
the NF1 tumor suppressor gene, which are consistent with the
diagnosis of MTT (32).
MTT is a rare, highly aggressive disease with a poor
prognosis, and no standardized treatment recommendations are
currently available. At present, the treatment of MTT is primarily
surgery, supplemented with radiotherapy and chemotherapy (12,14). A
meta-analysis reported that the 5-year survival rate of patients
with MTT was 14%, with a median overall survival time of 13 months
(15). Complete surgical resection
and local adjuvant radiotherapy are reported to improve patient
prognosis (33,34). However, radiotherapy processes vary
from center to center, including the choice of radiotherapy
technology and the way radiation doses are segmented. The commonly
used chemotherapeutic agents include ifosfamide, vincristine,
carboplatin and dactinomycin, but there is currently no consensus
on the optimal chemotherapy treatment (35). Angel et al (36) reported that neoadjuvant chemotherapy
followed by surgical resection and adjuvant chemotherapy is also a
treatment option for MTT. A number of studies have been conducted
ranging from bench work to clinical trials on hyperthermia combined
with chemoradiotherapy and targeted therapy to improve the
treatment effects on tumors, which confirmed the positive effects
of hyperthermia as an adjunctive therapy for treating tumors
(37–41).
MTT has an aggressive clinical course; the patient
in the present study was diagnosed with early local recurrence via
18F-FDG PET/CT 40 days after surgery. Following
multidisciplinary discussion, the postoperative therapeutics
included radiation therapy and deep hyperthermia, followed by
TKI-targeted therapy. TKIs are used to treat various tumors with
positive EGFR mutations, but TKIs also have adverse effects.
Obradovic et al (42)
reported that rashes and diarrhea are common side effects of TKI
therapy in patients with non-small cell lung cancer, and examined
the association between EGFR polymorphisms and TKI-associated
toxicities. This previous study revealed that out of nine EGFR
single-nucleotide polymorphisms related to TKI side effects,
rs11568315, rs712829 and rs712830 were associated with skin
toxicity. NSCLC carriers of long CA repeats (rs11568315, SL + LL)
were revealed to be more likely to develop TKI-associated skin
toxicity than short CA repeats (rs11568315, SS). Anlotinib
(43) is a novel multitarget TKI
that inhibits VEGFR2/3, fibroblast growth factor receptor 1–4,
platelet-derived growth factor receptor α/β and stem cell factor
receptor (cKit). The most common adverse event observed was
hypertension and other common adverse reactions included
hypothyroidism, hypertriglyceridemia, diarrhea and hand-foot
syndrome.
The primary treatment for MTT is surgery, with
adjuvant radiotherapy and chemotherapy, but the efficacy of these
treatments is currently unclear (16,17).
There is no unified standard for radiation therapy dosage. Previous
studies (12,44) reported cases treated with 52 Gy of
radiotherapy. In the present case, considering that the tumor was
located in the axilla and that high-dose radiotherapy may affect
the patient's limb movement and lymphatic return, a radiation dose
of 46 Gy was used, which was proven to be safe and effective.
PET/CT was used to guide the precise delineation of the target
area. Immunotherapy (IO) has shown efficacy in the treatment of
various tumor types (45–48), and PD-L1 expression is associated
with immune therapy efficacy and prognosis. Compared with low PD-L1
expression levels, high PD-L1 expression levels are associated with
a shorter survival time in lung cancer (49). The National Comprehensive Cancer
Network (50) guidelines recommend
IO combined with or without chemotherapy for patients with advanced
lung cancer, which has high expression of PD-L1. Zhou et al
(51) reported the case of a
patient who was misdiagnosed with hepatocellular carcinoma, who
received transcatheter arterial chemoembolization combined with
lenvatinib and pembrolizumab for 3 months. The patient subsequently
underwent surgery and was ultimately diagnosed with MTT using
postoperative pathology and immunohistochemistry. This was the
first application of PD-1 inhibition in MTT. In the present study,
the expression levels of PD-L1 were first detected to guide
treatment. As PD-L1 was negative, the TKI anlotinib was used to
treat the disease instead of IO, which was the first reported
application of anlotinib therapy in MTT.
To the best of our knowledge, the present case was
the first application of deep hyperthermia for MTT. Radiation
therapy and deep hyperthermia were well tolerated by the patient
without significant adverse effects. The patient developed
hypertension following the first cycle of TKI-targeted
administration, which was well controlled after antihypertensive
treatment (nifedipine controlled-release tablets 30 mg orally, once
daily). An MRI reexamination indicated that the tumor had entirely
disappeared after 1 cycle of TKI-targeted therapy. Currently, the
patient remains on anlotinib treatment with good tolerance. The
present study reported the use of TKI-targeted therapy with MTT,
and focused on its efficacy and adverse reactions. As of the latest
follow-up in October 2024, the patient had achieved a disease-free
survival (DFS) period of ~7 months, the patient was stable and
remained on anlotinib treatment with good tolerance. The issue of
the treatment duration with anlotinib and whether maintenance
therapy should be continued should be further examined.
In summary, MTT is a rare, highly aggressive disease
with a poor prognosis that is difficult to diagnose using
radiological imaging only. The present study reported the case of a
60-year-old patient diagnosed with MTT by the clinical features,
MRI, histopathology [e.g. Sox-10(+), S-100(+)] and genetic testing
(NGS of NF1 mutations and FISH) results, which demonstrated that
the tumor was PD-L1-negative. Following multidisciplinary
discussions, surgeons did not consider a second surgery. The
patient achieved a DFS of ~7 months and good tolerance after
undergoing PET/CT-guided moderate-dose radiotherapy,
anlotinib-targeted therapy and deep hyperthermia following surgical
recurrence. With no standardized treatment recommendations
available, the present study demonstrated that the combination of
surgery, radiation therapy, deep hyperthermia and targeted therapy
may provide a new strategy for the clinical treatment of MTT.
Supplementary Material
Supporting Data
Acknowledgements
Not applicable.
Funding
The present study was a self-funded research project supported
by the Autonomous Region Health Commission(grant nos. Z-B20231444
and Z-B20241428).
Availability of data and materials
The data generated in the present study may be
requested from the corresponding author. The data generated in the
present study using high-throughput next-generation sequencing may
be found in the National Center for Biotechnology Information
Sequence Read Archive under accession number PRJNA1182037 or at the
following URL: https://www.ncbi.nlm.nih.gov/sra/?term=PRJNA1182037.
Authors' contributions
YZ, LL and FL collected the data, including medical
images and clinical information, and wrote the original draft. YZ
advised on patient treatment. LL and FL analyzed patient data. DH
and LQ made substantial contributions to study conception and
design, and reviewed and edited the manuscript. YZ and LQ confirm
the authenticity of all the raw data All authors read and approved
the final version of the manuscript.
Ethics approval and consent to
participate
The present study was conducted in accordance with
the guidelines of The Declaration of Helsinki and was approved
(approval no. KY2024521) by the Ethics Committee of The Liuzhou
Worker's Hospital (Liuzhou, China) to ensure that patient
information was not misused and privacy information was not leaked,
in order to protect the rights and interests of the patient.
Written informed consent was obtained from the patient.
Patient consent for publication
Written informed consent was obtained from the
patient for publication of the data and the images in this case
report.
Competing interests
The authors declare that they have no competing
interests.
References
|
1
|
Knight SWE, Knight TE, Santiago T, Murphy
AJ and Abdelhafeez AH: Malignant peripheral nerve sheath Tumors-A
comprehensive review of pathophysiology, diagnosis, and
multidisciplinary management. Children (Basel 9). 382022.
|
|
2
|
Cai Z, Tang X, Liang H, Yang R, Yan T and
Guo W: Prognosis and risk factors for malignant peripheral nerve
sheath tumor: A systematic review and meta-analysis. World J Surg
Oncol. 18:2572020. View Article : Google Scholar : PubMed/NCBI
|
|
3
|
Ferner RE and Gutmann DH: International
consensus statement on malignant peripheral nerve sheath tumors in
neurofibromatosis. Cancer Res. 62:1573–1577. 2002.PubMed/NCBI
|
|
4
|
Riad S, Biau D, Holt GE, Werier J,
Turcotte RE, Ferguson PC, Griffin AM, Dickie CI, Chung PW, Catton
CN, et al: The clinical and functional outcome for patients with
radiation-induced soft tissue sarcoma. Cancer. 118:2682–2692. 2012.
View Article : Google Scholar : PubMed/NCBI
|
|
5
|
Widemann BC: Current status of sporadic
and neurofibromatosis type 1-associated malignant peripheral nerve
sheath tumors. Curr Oncol Rep. 11:322–328. 2009. View Article : Google Scholar : PubMed/NCBI
|
|
6
|
Okada K, Hasegawa T, Tajino T, Hotta T,
Yanagisawa M, Osanai T, Nishida J, Seki K and Itoi E: Clinical
relevance of pathological grades of malignant peripheral nerve
sheath tumor: A multi-institution TMTS study of 56 cases in
Northern Japan. Ann Surg Oncol. 14:597–604. 2007. View Article : Google Scholar : PubMed/NCBI
|
|
7
|
Louis DN, Ohgaki H, Wiestler OD, Cavenee
WK, Burger PC, Jouvet A, Scheithauer BW and Kleihues P: The 2007
WHO classification of tumours of the central nervous system. Acta
Neuropathol. 114:972007. View Article : Google Scholar : PubMed/NCBI
|
|
8
|
Rodriguez FJ, Folpe AL, Giannini C and
Perry A: Pathology of peripheral nerve sheath tumors: Diagnostic
overview and update on selected diagnostic problems. Acta
Neuropathol. 123:295–319. 2012. View Article : Google Scholar : PubMed/NCBI
|
|
9
|
Le Guellec S, Decouvelaere AV, Filleron T,
Valo I, Charon-Barra C, Robin YM, Terrier P, Chevreau C and Coindre
JM: Malignant peripheral nerve sheath tumor is a challenging
diagnosis: A systematic pathology review, immunohistochemistry, and
molecular analysis in 160 patients from the French sarcoma group
database. Am J Surg Pathol. 40:896–908. 2016. View Article : Google Scholar : PubMed/NCBI
|
|
10
|
Goertz O, Langer S, Uthoff D, Ring A,
Stricker I, Tannapfel A and Steinau HU: Diagnosis, treatment and
survival of 65 patients with malignant peripheral nerve sheath
tumors. Anticancer Res. 34:777–783. 2014.PubMed/NCBI
|
|
11
|
Bradford D and Kim A: Current treatment
options for malignant peripheral nerve sheath tumors. Curr Treat
Options Oncol. 16:3282015. View Article : Google Scholar : PubMed/NCBI
|
|
12
|
Li G, Liu C, Liu Y, Xu F, Su Z, Wang Y,
Ren S, Deng T, Huang D, Tian Y and Qiu Y: Analysis of clinical
features and prognosis of malignant triton tumor: A report of two
cases and literature review. Oncol Lett. 10:3551–3556. 2015.
View Article : Google Scholar : PubMed/NCBI
|
|
13
|
Kamran SC, Howard SA, Shinagare AB,
Krajewski KM, Jagannathan JP, Hornick JL and Ramaiya NH: Malignant
peripheral nerve sheath tumors: Prognostic impact of
rhabdomyoblastic differentiation (malignant triton tumors),
neurofibromatosis 1 status and location. Eur J Surg Oncol.
39:46–52. 2013. View Article : Google Scholar : PubMed/NCBI
|
|
14
|
Tsimpinos M, Pigadiotis E, Kontaxis V and
Lioulias A: Giant malignant triton tumour of the posterior
mediastinum. Interact Cardiovasc Thorac Surg. 33:657–659. 2021.
View Article : Google Scholar : PubMed/NCBI
|
|
15
|
McConnell YJ and Giacomantonio CA:
Malignant triton tumors-complete surgical resection and adjuvant
radiotherapy associated with improved survival. J Surg Oncol.
106:51–56. 2012. View Article : Google Scholar : PubMed/NCBI
|
|
16
|
Bins RB, Pinzon CE, da Silva Pereira LD,
Bertuol M, Isolan P and Takamatu EE: Malignant triton tumor of the
kidney in a child: A case report. Int J Surg Case Rep.
85:1062522021. View Article : Google Scholar : PubMed/NCBI
|
|
17
|
Zhao A, Ding D, Li X and Wang J: Malignant
triton tumor in a child: Case report and literature review. Cancer
Manag Res. 11:10759–10766. 2019. View Article : Google Scholar : PubMed/NCBI
|
|
18
|
Stasik CJ and Tawfik O: Malignant
peripheral nerve sheath tumor with rhabdomyosarcomatous
differentiation (malignant triton tumor). Arch Pathol Lab Med.
130:1878–1881. 2006. View Article : Google Scholar : PubMed/NCBI
|
|
19
|
Lai Z, Markovets A, Ahdesmaki M, Chapman
B, Hofmann O, McEwen R, Johnson J, Dougherty B, Barrett JC and Dry
JR: VarDict: A novel and versatile variant caller for
next-generation sequencing in cancer research. Nucleic Acids Res.
44:e1082016. View Article : Google Scholar : PubMed/NCBI
|
|
20
|
Amin MB, Greene FL, Edge SB, Compton CC,
Gershenwald JE, Brookland RK, Meyer L, Gress DM, Byrd DR and
Winchester DP: The eighth edition AJCC cancer staging manual:
Continuing to build a bridge from a population-based to a more
‘personalized’ approach to cancer staging. CA Cancer J Clin.
67:93–99. 2017. View Article : Google Scholar : PubMed/NCBI
|
|
21
|
Masson P: Recklinghausen's
neurofibromatosis, sensory neuromas and motor neuromas. libman
anniversary New York. 1932.
|
|
22
|
Woodruff JM, Chernik NL, Smith MC, Millett
WB and Foote FW Jr: Peripheral nerve tumors with
rhabdomyosarcomatous differentiation (malignant ‘Triton’ tumors).
Cancer. 32:426–439. 1973. View Article : Google Scholar : PubMed/NCBI
|
|
23
|
de Traux de Wardin H, Dermawan JK, Vanoli
F, Jiang SC, Singer S, Chi P, Tap W, Wexler LH and Antonescu CR:
NF1-Driven rhabdomyosarcoma phenotypes: A comparative clinical and
molecular study of NF1-Mutant rhabdomyosarcoma and NF1-associated
malignant triton tumor. JCO Precis Oncol. 8:e23005972024.
View Article : Google Scholar : PubMed/NCBI
|
|
24
|
Marcel AD, Aleksandar M, Rainer H,
Grüneisen JS, Haubold J, Opitz MK, Bauer S, Umutlu L, Forsting M
and Schaarschmidt BM: Impact of CT and MRI in the diagnostic workup
of malignant triton tumour-a monocentric analysis and review of the
literature. Br J Radiol. 97:430–438. 2024. View Article : Google Scholar
|
|
25
|
Karamchandani JR, Nielsen TO, van de Rijn
M and West RB: Sox10 and S100 in the diagnosis of soft-tissue
neoplasms. Appl Immunohistochem Mol Morphol. 20:445–450. 2012.
View Article : Google Scholar : PubMed/NCBI
|
|
26
|
Otsuka H, Kohashi K, Yoshimoto M, Ishihara
S, Toda Y, Yamada Y, Yamamoto H, Nakashima Y and Oda Y:
Immunohistochemical evaluation of H3K27 trimethylation in malignant
peripheral nerve sheath tumors. Pathol Res Pract. 214:417–425.
2018. View Article : Google Scholar : PubMed/NCBI
|
|
27
|
Jurisic V, Radenkovic S and Konjevic G:
The actual role of LDH as tumor marker, biochemical and clinical
aspects. Adv Exp Med Biol. 867:115–124. 2015. View Article : Google Scholar : PubMed/NCBI
|
|
28
|
Judith VMGB: Jason L. Hornick: Practical
soft tissue pathology: A diagnostic approach, 2nd edition. Virchows
Arch. 473:785–786. 2018. View Article : Google Scholar : PubMed/NCBI
|
|
29
|
Mokhtari M, Safavi D, Soleimani N,
Monabati A and Safaei A: Carcinoma of unknown primary origin:
Application of immunohistochemistry with emphasis to different
cytokeratin 7 and 20 staining patterns. Appl Immunohistochem Mol
Morphol. 30:623–634. 2022. View Article : Google Scholar : PubMed/NCBI
|
|
30
|
Tuffaha MMSA, Guski H and Kristiansen G:
Immunohistochemistry in Tumor Diagnostics. 2017.
|
|
31
|
Yurina M and Khin T: Malignant peripheral
nerve sheath tumor with divergent glandular differentiation. Int J
Surg Pathol. 25:310–313. 2017. View Article : Google Scholar : PubMed/NCBI
|
|
32
|
Who WHO, . WHO Classification of Tumours
of Soft Tissue and Bone: WHO Classification of Tumours. vol. 5:WHO
classification of tumours of soft tissue and bone. 2013.
|
|
33
|
AlAli B and Amr S: Malignant glandular
triton tumor arising in the radial nerve with prolonged survival: A
case report and review of the literature. Case Rep Pathol.
2021:46141852021.PubMed/NCBI
|
|
34
|
Yasuda M, Muto Y, Kuremoto T, Murakami K,
Onisihi T, Koida A, Inui T and Hisa Y: A case of recurrent
malignant triton tumor successfully treated with radiotherapy.
Auris Nasus Larynx. 43:710–714. 2016. View Article : Google Scholar : PubMed/NCBI
|
|
35
|
Ailing Z, Daling D, Xueqin L and Jiangtao
W: Malignant triton tumor in a child: Case report and literature
review. Cancer Manag Res. 11:10759–10766. 2020.PubMed/NCBI
|
|
36
|
Angel G, Jose Luis P, David R and
Francisco B: Malignant triton tumor of the kidney. New location not
previously reported. Urol Int. 99:121–123. 2015.
|
|
37
|
Ba MC, Long H, Cui SZ, Gong YF, Yan ZF,
Wang S and Wu YB: Mild hyperthermia enhances sensitivity of gastric
cancer cells to chemotherapy through reactive oxygen
species-induced autophagic death. Tumour Biol.
39:10104283177119522017. View Article : Google Scholar : PubMed/NCBI
|
|
38
|
Ohguri T, Harima Y, Imada H, Sakurai H,
Ohno T, Hiraki Y, Tuji K, Tanaka M and Terashima H: Relationships
between thermal dose parameters and the efficacy of definitive
chemoradiotherapy plus regional hyperthermia in the treatment of
locally advanced cervical cancer: Data from a multicentre
randomised clinical trial. Int J Hyperthermia. 34:461–468. 2017.
View Article : Google Scholar : PubMed/NCBI
|
|
39
|
Wang Y, Zou L, Qiang Z, Jiang J, Zhu Z and
Ren J: Enhancing targeted cancer treatment by combining
hyperthermia and radiotherapy using Mn-Zn ferrite magnetic
nanoparticles. ACS Biomater Sci Eng. 6:3550–3562. 2020. View Article : Google Scholar : PubMed/NCBI
|
|
40
|
Yang H, Li M and Mei T: Survival benefit
of thermal ablation combined with chemotherapy for the treatment of
stage IV nonsmall cell lung cancer: A propensity-matched analysis.
Int J Hyperthermia. 39:348–357. 2022. View Article : Google Scholar : PubMed/NCBI
|
|
41
|
Zhou Y, Zhong Q, Huang D, Qin L, Huang J,
Wang C, Chen B, Chen M, Li Y and Liu W: The efficacy of adding
hyperthermia to the treatment of advanced NSCLC patients based on
the states of EGFR. Aging (Albany NY). 14:5223–5232. 2022.
View Article : Google Scholar : PubMed/NCBI
|
|
42
|
Obradovic J, Todosijevic J and Jurisic V:
Side effects of tyrosine kinase inhibitors therapy in patients with
non-small cell lung cancer and associations with EGFR
polymorphisms: A systematic review and meta-analysis. Oncol Lett.
25:622023. View Article : Google Scholar : PubMed/NCBI
|
|
43
|
Si X, Zhang L, Wang H, Zhang X, Wang M,
Han B, Li K, Wang Q, Shi J, Wang Z, et al: Management of
anlotinib-related adverse events in patients with advanced
non-small cell lung cancer: Experiences in ALTER-0303. Thorac
Cancer. 10:551–556. 2019. View Article : Google Scholar : PubMed/NCBI
|
|
44
|
Chaudhry I, Algazal T, Cheema A, Al Faraj
A, Al Malki N, Mutairi H, Abbas A and Amr S: Mediastinal malignant
triton tumor: A rare case series and review of literature. Int J
Surg Case Rep. 62:115–119. 2019. View Article : Google Scholar : PubMed/NCBI
|
|
45
|
Chow LQM, Haddad R, Gupta S, Mahipal A,
Mehra R, Tahara M, Berger R, Eder JP, Burtness B, Lee SH, et al:
Antitumor activity of pembrolizumab in Biomarker-unselected
patients with recurrent and/or metastatic head and neck squamous
cell carcinoma: Results from the phase Ib KEYNOTE-012 expansion
cohort. J Clin Oncol. 34:3838–3845. 2016. View Article : Google Scholar : PubMed/NCBI
|
|
46
|
Liu SV, Reck M, Mansfield AS, Mok T,
Scherpereel A, Reinmuth N, Garassino MC, De Castro Carpeno J,
Califano R, Nishio M, et al: Updated overall survival and PD-L1
subgroup analysis of patients with extensive-stage small-cell lung
cancer treated with atezolizumab, carboplatin, and etoposide
(IMpower133). J Clin Oncol. 39:619–630. 2021. View Article : Google Scholar : PubMed/NCBI
|
|
47
|
Overman MJ, Lonardi S, Wong KYM, Lenz HJ,
Gelsomino F, Aglietta M, Morse MA, Van Cutsem E, McDermott R, Hill
A, et al: Durable clinical benefit with nivolumab plus ipilimumab
in DNA mismatch Repair-Deficient/microsatellite Instability-high
metastatic colorectal cancer. J Clin Oncol. 36:773–779. 2018.
View Article : Google Scholar : PubMed/NCBI
|
|
48
|
Amin S and Lin C: Immunotherapy plus
chemoradiation improves overall survival in stage IV esophageal
cancer: A cohort study. Gastro Hep Adv. 3:302–310. 2024. View Article : Google Scholar : PubMed/NCBI
|
|
49
|
Brody R, Zhang Y, Ballas M, Siddiqui MK,
Gupta P, Barker C, Midha A and Walker J: PD-L1 expression in
advanced NSCLC: Insights into risk stratification and treatment
selection from a systematic literature review. Lung Cancer.
112:200–215. 2017. View Article : Google Scholar : PubMed/NCBI
|
|
50
|
Ettinger DS, Wood DE, Aisner DL, Akerley
W, Bauman J, Chirieac LR, D'Amico TA, DeCamp MM, Dilling TJ,
Dobelbower M, et al: Non-small cell lung cancer, version 5.2017,
NCCN clinical practice guidelines in oncology. J Natl Compr Canc
Netw. 15:504–535. 2017. View Article : Google Scholar : PubMed/NCBI
|
|
51
|
Zhou B, Zhan C, Tian Y, Gao Z and Yan S:
Primary hepatic malignant triton tumor mimicking hepatocellular
carcinoma by demonstrating arterial-phase hypervascularity and
subsequent washout on dynamic contrast-enhanced imaging: A case
report and literature review. Front Med (Lausanne). 11:13616902024.
View Article : Google Scholar : PubMed/NCBI
|